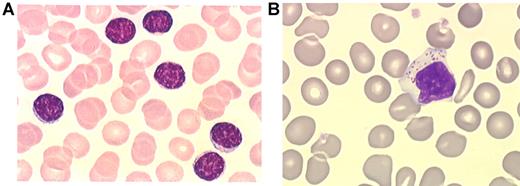
Figure 2. Small and large granular lymphocytes. Distinction between small lymphocytes (A) and large granular lymphocytes (B) on blood smears. Micrographs were viewed with a Leica Leitz DMRB microscope using a 100×/1.30 oil immersion objective. Images were captured with a Sony Exwave HAD camera and manipulated using Tribyn Version 1.3 software.

Abstract
Large granular lymphocyte (LGL) leukemia is characterized by a clonal expansion of either CD3+ cytotoxic T or CD3− NK cells. Prominent clinical features of T-LGL leukemia include neutropenia, anemia and rheumatoid arthritis (RA). The terminal effector memory phenotype (CD3+/CD45RA+/CD62L−CD57+) of T-LGL suggests a pivotal chronic antigen-driven immune response. LGL survival is then promoted by platelet-derived growth factor and interleukin-15, resulting in global dysregulation of apoptosis and resistance to normal pathways of activation-induced cell death. These pathogenic features explain why treatment of T-LGL leukemia is based on immunosuppressive therapy. The majority of these patients eventually need treatment because of severe or symptomatic neutropenia, anemia, or RA. No standard therapy has been established because of the absence of large prospective trials. The authors use low-dose methotrexate initially for T-LGL leukemia patients with neutropenia and/or RA. We recommend either methotrexate or oral cyclophosphamide as initial therapy for anemia. If treatment is not successful, patients are switched to either the other agent or cyclosporine. The majority of patients experience an indolent clinical course. Deaths infrequently occur because of infections related to severe neutropenia. As there are no curative therapeutic modalities for T-LGL leukemia, new treatment options are needed.
Introduction
Large granular lymphocyte (LGL) leukemia was first described in 1985 as a clonal disorder involving tissue invasion of marrow, spleen, and liver.1 Clinical presentation is dominated by recurrent infections associated with neutropenia, anemia, splenomegaly, and autoimmune diseases, particularly rheumatoid arthritis (RA).2-4 In 1989, the French-American-British classification identified LGL leukemia as a distinct entity among chronic T-lymphoid leukemias.5 In 1993, the distinction was made between CD3+ T-cell and CD3− NK-cell lineage subtypes of LGL leukemia.2 The REAL classification in 1994 recommended that LGL leukemia be a distinct clinical entity among peripheral T-cell and NK-cell neoplasms and adopted the suggestion of distinguishing the 2 subtypes of T-cell and NK-cell LGL leukemia.6 The World Health Organization classification published in 1999 included T- or NK-cell granular lymphocytic leukemia in the subgroup of mature peripheral T-cell neoplasms.7 Furthermore, in 2008, a new provisional entity of chronic lymphoproliferative disorder of NK cells (also known as chronic NK-cell lymphocytosis) was created by World Health Organization to distinguish it from the much more aggressive form of NK-cell leukemia (Table 1).8 The frequency of T and NK LGL leukemia is not accurately determined and ranges from 2% to 5% of the chronic lymphoproliferative diseases in North America and up to 5% to 6% in Asia.
History of the classification of LGL leukemia
| FAB (1989) . | REAL (1994) . | WHO (1999) . | WHO (2008) . |
|---|---|---|---|
| Chronic T lymphoid leukemias | T-cell and putative NK-cell neoplasms | Mature (peripheral) T-cell neoplasms | Mature T-cell and NK-cell neoplasms |
| T-cell CLL or LGL leukemia | T-cell chronic lymphocytic leukemia/prolymphocytic | T-cell granular lymphocytic leukemia | T-cell granular lymphocytic leukemia |
| T prolymphocytic leukemia | LGL leukemia | Aggressive NK-cell leukemia | Chronic lymphoproliferative disorder of NK cells* |
| T-cell type | |||
| Adult T-cell leukemia/ lymphoma | NK-cell type | ||
| Sezary syndrome | Aggressive NK-cell leukemia |
| FAB (1989) . | REAL (1994) . | WHO (1999) . | WHO (2008) . |
|---|---|---|---|
| Chronic T lymphoid leukemias | T-cell and putative NK-cell neoplasms | Mature (peripheral) T-cell neoplasms | Mature T-cell and NK-cell neoplasms |
| T-cell CLL or LGL leukemia | T-cell chronic lymphocytic leukemia/prolymphocytic | T-cell granular lymphocytic leukemia | T-cell granular lymphocytic leukemia |
| T prolymphocytic leukemia | LGL leukemia | Aggressive NK-cell leukemia | Chronic lymphoproliferative disorder of NK cells* |
| T-cell type | |||
| Adult T-cell leukemia/ lymphoma | NK-cell type | ||
| Sezary syndrome | Aggressive NK-cell leukemia |
Provisional entity.
How we diagnose LGL leukemia
The diagnosis of LGL leukemia is established by documentation of increased numbers of clonal LGL, occurring in an appropriate clinical context9 (Figure 1).
How to establish the diagnosis of LGL leukemia. The diagnosis of LGL leukemia is made on the following criteria: common criteria of LGL leukemia. The diagnosis is based on a LGL peripheral expansion (> 0.5 × 109/L). Specific criteria for T-LGL leukemia include: expression of LGL surface markers compatible with an activated T-cell (commonly CD3+/CD8+/CD57+ and/or CD16+) phenotype; and clonal rearrangement of TCR-γ gene using PCR or specific and clonal Vβ expression using FCM. Specific criteria for NK-LGL leukemia and NK-LGL lymphocytosis include: expression of LGL surface markers compatible with an NK cell (commonly CD3−/CD8+/CD16+ and/or CD16+/CD56+) phenotype. The term chronic NK-LGL lymphocytosis is used for patients with relatively few symptoms and chronic illness, whereas patients with massive tissue LGL infiltration of the spleen, liver, and bone marrow and presenting aggressive clinical behavior are considered as having NK-LGL leukemia.
How to establish the diagnosis of LGL leukemia. The diagnosis of LGL leukemia is made on the following criteria: common criteria of LGL leukemia. The diagnosis is based on a LGL peripheral expansion (> 0.5 × 109/L). Specific criteria for T-LGL leukemia include: expression of LGL surface markers compatible with an activated T-cell (commonly CD3+/CD8+/CD57+ and/or CD16+) phenotype; and clonal rearrangement of TCR-γ gene using PCR or specific and clonal Vβ expression using FCM. Specific criteria for NK-LGL leukemia and NK-LGL lymphocytosis include: expression of LGL surface markers compatible with an NK cell (commonly CD3−/CD8+/CD16+ and/or CD16+/CD56+) phenotype. The term chronic NK-LGL lymphocytosis is used for patients with relatively few symptoms and chronic illness, whereas patients with massive tissue LGL infiltration of the spleen, liver, and bone marrow and presenting aggressive clinical behavior are considered as having NK-LGL leukemia.
LGLs are identified by their specific morphology and phenotype. They display a large size (15-18 μm), an abundant cytoplasm containing typical azurophilic granules, and a reniform or round nucleus (Figure 2). The normal number of LGLs in peripheral blood is 0.25 × 109/L.1 The initial series published 20 years ago reported that more than 80% of the patients presented with a lymphocytosis ranging between 2 × 109 and 10 × 109 LGL/L.2,10 It explains why a LGL count more than 2 × 109/L was considered as mandatory, but it is now recognized that a lower count (range, 0.4-2 × 109/L) may be compatible with the diagnosis.11-13 It is acknowledged by the authors that the diagnosis is difficult in such patients. In such cases, the diagnosis is more easily supported if patients exhibit typical clinical or hematologic presentations or autoimmune diseases, such as RA. We also recommend that marrow aspirate and/or biopsy with immunohistochemistry be performed to aid in diagnosis in such patients. Documentation of lymphoid interstitial infiltration with linear arrays of CD8, granzyme B, perforin, and/or TIA-1 positivity supports the diagnosis of T-LGL leukemia (Figure 3).14-16
Small and large granular lymphocytes. Distinction between small lymphocytes (A) and large granular lymphocytes (B) on blood smears. Micrographs were viewed with a Leica Leitz DMRB microscope using a 100×/1.30 oil immersion objective. Images were captured with a Sony Exwave HAD camera and manipulated using Tribyn Version 1.3 software.
Small and large granular lymphocytes. Distinction between small lymphocytes (A) and large granular lymphocytes (B) on blood smears. Micrographs were viewed with a Leica Leitz DMRB microscope using a 100×/1.30 oil immersion objective. Images were captured with a Sony Exwave HAD camera and manipulated using Tribyn Version 1.3 software.
Bone marrow features of T-LGL leukemia. Hematoxylin and eosin staining of marrow biopsy reveals a slightly hypercellular marrow with subtle increase in interstitial lymphocytes, as shown by arrow (left). Immunohistochemistry analyses (right) highlight the presence of intrasinusoidal cytotoxic T-cell infiltrates, staining positive for CD8 (arrow) and granzyme B (inset). Micrographs were viewed with a Leica Leitz DMRB microscope using a 100×/1.30 oil immersion objective. Images were captured with a Sony Exwave HAD camera and manipulated using Tribyn Version 1.3 software.
Bone marrow features of T-LGL leukemia. Hematoxylin and eosin staining of marrow biopsy reveals a slightly hypercellular marrow with subtle increase in interstitial lymphocytes, as shown by arrow (left). Immunohistochemistry analyses (right) highlight the presence of intrasinusoidal cytotoxic T-cell infiltrates, staining positive for CD8 (arrow) and granzyme B (inset). Micrographs were viewed with a Leica Leitz DMRB microscope using a 100×/1.30 oil immersion objective. Images were captured with a Sony Exwave HAD camera and manipulated using Tribyn Version 1.3 software.
How we diagnose T-LGL leukemia
T-LGL leukemias constitutively show a mature postthymic phenotype with some degree of heterogeneity. The great majority of cases of T-LGL leukemia show a CD3+, T-cell receptor (TCR)-αβ+, CD4−, CD5dim, CD8+, CD16+, CD27−, CD28−, CD45R0−, CD57+ phenotype, which reflects a constitutively activated T-cell phenotype.17-19 Based on CD45RA and CD62L expression, which defines 4 distinct subpopulations of naive and memory T cells, we have shown that T-LGL leukemic cells display a terminal-effector memory phenotype defined by the expression of CD45RA and lack of CD62L expression.20 Some cases express CD4 antigen with or without coexpression of CD8.21 Leukemic LGLs constitutively express IL2 Rβ (p75, CD122) but not IL2 Rα (p55, CD25) as well as perforin and granzyme B, which are components of the cytoplasmic granules found only in NK cells or cytotoxic T lymphocytes.22,23 Less than 10% of cases are TCR-γδ+.24,25 They do not differ from αβ cases, except for a CD4−/CD8− phenotype similar to their normal counterparts. Fas (CD95) and Fas-Ligand (CD178) are expressed in the majority of cases.26,27
Clonality of T-LGL is now routinely demonstrated using TCR-γ-polymerase chain reaction (PCR) analyses rather than Southern blot. Evidence of TCR-γ gene rearrangement makes the distinction of clonal LGL leukemia from reactive LGL proliferations. Vβ TCR gene repertoire analysis is also assessed using flow cytometry (FCM) and may facilitate the demonstration of clonality.28,29 The current Vβ monoclonal antibody panel covers 75% of the Vβ spectrum. Although a unique pattern of Vβ usage is not universally recognized as a criterion of monoclonality, we and others have observed a very high correlation between Vβ FCM and TCR-γ-PCR results in detecting clonality. Vβ FCM may detect 3 different patterns of patients: those with a unique Vβ expansion (Figure 4A), others with 2 or 3 specific expanded clones, and finally those with a so-called defective pattern in which the relevant Vβ monoclonal antibody is not available. The significance of monoclonality in T cells remains a matter of debate. A significant proportion of healthy elderly persons display benign monoclonal CD3+/CD8+ T-cell expansions, which do not differ phenotypically from those observed in T-LGL patients.19,30 These cases of so-called T-cell clonopathy of unknown significance may overlap with indolent T-LGL leukemia.
Flow cytometry analysis in LGL leukemia. (A) Blue: Normal nonclonal CD3+ T cells showing a polyclonal Vβ repertoire pattern. Red: LGL population showing a CD3+/CD8+/CD5dim phenotype with a unique clonal Vβ7.1 expression (> 92%). (B) The NK CD3− LGL population strongly expresses the CD94/KIR ag.
Flow cytometry analysis in LGL leukemia. (A) Blue: Normal nonclonal CD3+ T cells showing a polyclonal Vβ repertoire pattern. Red: LGL population showing a CD3+/CD8+/CD5dim phenotype with a unique clonal Vβ7.1 expression (> 92%). (B) The NK CD3− LGL population strongly expresses the CD94/KIR ag.
Distribution of NK activating receptors has been examined in T-LGL leukemia, and expression of CD94 is not uncommon.31 Other receptors for class I major histocompatibility complex molecules are abnormally expressed.32 A monotypic expression pattern of killer immunoglobin-like receptors (KIR) can be found using monoclonal antibodies to CD158a, CD158b, and CD158e (corresponding to the most prevalent KIR genes) in more than half of the patients.33
How we diagnose NK-LGL leukemia and NK lymphocytosis
Both subtypes display the following phenotype: CD2+, s CD3−, CD3ϵ+, TCR-αβ−, CD4−, CD8+, CD16+, CD56+. CD57 is variably expressed.2,34 None of these CD3− LGL leukemia cases shows rearrangement of TCR genes. Clonality of NK-LGL leukemia is difficult to assess. Chromosomal abnormalities may help in this setting. CD94 and activating isoforms of KIRs are preferentially expressed in chronic NK-cell lymphocytosis concomitantly with a reduced expression of natural cytotoxicity receptors (Figure 4B).35,36
How we understand the pathophysiology of LGL leukemic expansion
Dysregulated apoptosis has been shown to be an important mechanism in the pathogenesis of LGL leukemia either of T- or NK-cell origin. Unlike their normal counterparts, leukemic LGLs are activated cytotoxic cells that escaped Fas-mediated activation-induced cell death. Increased numbers of circulating leukemic LGLs then result from activation of multiple survival pathways. Constitutive activation of JAK2/signal transducer and activator of transcription 3/Mcl-1, RAS/MAPK, and SFK/PI3K/AKT and sphingolipid signaling pathways has been demonstrated in leukemic LGLs.12,37-41 More recently, we have shown, using a systems biology approach, that interleukin-15 and platelet-derived growth factor are master regulators in facilitating LGL survival.41-43
The etiology of the T-cell form of LGL leukemia is not known. The terminal effector memory phenotype of leukemic LGL suggests response to chronic antigen exposure. This hypothesis is also supported by the finding that sequencing of the antigen-specific portion of the T-cell receptor suggested nonrandom antigen-driven clonal selection.44 The peptide(s) involved in initial expansion have not been discovered. However, some data suggest that chronic activation by a virus with structural similarity to the human T-cell leukemia virus retroviral family may contribute to this process.45-47
Clinical features and outcome of T-LGL leukemia
T-LGL leukemia commonly affects either men or women with the same proportion at a median age of 60 years (range, 12-87 years). Only 20% to 25% of patients are younger than 50 years. The majority of patients are symptomatic at the time of presentation. Splenomegaly is observed in 25% to 50% of cases, whereas hepatomegaly and lymphadenopathy are very rarely observed.2,9,12,13 RA is present in 11% to 36% of patients and is mostly diagnosed before the onset of LGL leukemia.
Recurrent infections associated with neutropenia occur in 15% to 56% of patients. The majority of infections present with mucocutaneous or respiratory involvement. Although very few series of NK chronic lymphocytosis have been published, no significant differences in clinical and biologic features are observed between the 2 entities other than that RA is less frequently observed.12,48 Diseases associated with T-LGL leukemia are listed in Table 2. Various autoimmune diseases and viral infections may be associated with T-LGL leukemia; T-LGL leukemia has also been observed after organ or stem cell transplantation.49-54 Very rarely, pulmonary artery hypertension has been observed.48,55,56 In such cases, pulmonary vascular endothelial damage may result from cytotoxic activity of leukemic LGL through DAP10/DAP12 signaling.57
Diseases associated with T-LGL leukemia
| Associated diseases . | Frequency, % . |
|---|---|
| Autoimmune diseases | 15-40 |
| RA | 11-36 |
| Sjogren syndrome | CR |
| Polymyositis | CR |
| PMR | CR |
| Multineuritis | CR |
| Vasculitis | CR |
| Endocrinopathy | CR |
| Celiac disease | CR |
| CIBD | CR |
| APECED | CR |
| Autoimmune cytopenia* | 5-10 |
| PRCA | 5 |
| AIHA | < 2 |
| ITP | Rare |
| Cyclic neutropenia | Rare |
| Pulmonary hypertension | Rare |
| Neoplasia | < 10 |
| Solid tumors | < 4 |
| Myelodysplasia | < 4 |
| B-cell malignancies | 5-7 |
| CML treated with dasatinib | Recently described |
| Viral infection (HIV, CMV, HCV, EBV) | Rare |
| Posttransplantation | |
| Solid and hematopoietic stem cell transplantation | Rare |
| Associated diseases . | Frequency, % . |
|---|---|
| Autoimmune diseases | 15-40 |
| RA | 11-36 |
| Sjogren syndrome | CR |
| Polymyositis | CR |
| PMR | CR |
| Multineuritis | CR |
| Vasculitis | CR |
| Endocrinopathy | CR |
| Celiac disease | CR |
| CIBD | CR |
| APECED | CR |
| Autoimmune cytopenia* | 5-10 |
| PRCA | 5 |
| AIHA | < 2 |
| ITP | Rare |
| Cyclic neutropenia | Rare |
| Pulmonary hypertension | Rare |
| Neoplasia | < 10 |
| Solid tumors | < 4 |
| Myelodysplasia | < 4 |
| B-cell malignancies | 5-7 |
| CML treated with dasatinib | Recently described |
| Viral infection (HIV, CMV, HCV, EBV) | Rare |
| Posttransplantation | |
| Solid and hematopoietic stem cell transplantation | Rare |
PMR indicates polymyalgia rheumatica; CIBD, chronic inflammatory bowel disease; APECED, autoimmune polyendocrinopathy-candidosis-ectodermal dystrophy; PRCA, pure red cell aplasia; AIHA, autoimmune hemolytic anemia; ITP, idiopathic thrombocytopenic purpura; CML, chronic myeloid leukemia; CMV, cytomegalovirus; HCV, hepatitis C virus; EBV, Epstein-Barr virus; and CR, case report.
Excluding chronic neutropenia.
The hematologic features of T-LGL leukemia have been recently updated in a large cohort of 229 cases of the French registry and compared with the other large series.12 Lymphocytosis (> 4 × 109/L) related to an LGL excess is observed in more than half of patients. The mean absolute circulating LGL count varied widely ranging from 0.5 × 109/L to 10 × 109/L. A total of 5% to 35% of patients were transfusion-dependent. Rheumatoid factor and antinuclear antibodies were detected in 40% to 60% of cases. Hypergammaglobulinemia was commonly observed (38%), whereas monoclonal gammopathy was reported in less than 15% of patients. High serum β2-microglobulin level was detected in two-thirds of the patients, and elevated soluble Fas-L was observed in the majority of cases examined.27,58 LGL marrow infiltration was detected in more than 70% of cases. However, there is not a good correlation between the extent of marrow infiltration with LGL leukemic cells and the degree of cytopenias or severity of systemic symptoms.
The T-cell form of LGL leukemia is an indolent disease and is considered as a chronic illness. The first large series reported 26 deaths among 151 patients after a mean follow-up of 23 months.10 Our early observations demonstrated 9 deaths in a series of 25 patients followed for more than 2 years, primarily resulting from infectious causes.2 In contrast, Dhodapkar et al reported a superior median survival of 10 years in 68 patients.59 In our recent French series, 15 of 229 LGL leukemia patients died mostly related to neutropenia-associated sepsis.12 It is difficult to evaluate the exact percentage of patients who will finally require therapy. It varies from 33% to 80% in reported series. This variability regarding the clinical behavior and outcome may be related to differences in disease definition used in these series as well as the duration of follow-up. Nevertheless, although some very rare cases of spontaneous remission have been described,60 it appears that the majority of patients will require treatment sometime during 10 years of disease observation.
Aggressive NK LGL leukemia patients present with organomegaly, B symptoms, a high LGL count, and massive LGL marrow infiltration. They are mostly reported in Asia and are associated with Epstein-Barr virus. The prognosis is very poor in these cases because patients are refractory to any treatments.2,61,62
When do we institute therapy?
Both T-LGL leukemia and chronic NK-cell lymphocytosis pursue a chronic clinical course. Therefore, recommendations regarding therapy are similar for these 2 disorders; the remaining sections of this article pertain to both of these disorders. Indications for treatment include (1) severe neutropenia (absolute neutrophil count [ANC] < 500); (2) moderate neutropenia (ANC > 500) symptomatic from recurrent infections; (3) symptomatic or transfusion-dependent anemia; and (4) associated autoimmune conditions requiring therapy, most often RA. Both of us have observed patients who despite severe neutropenia have remained well for extended periods and are reluctant to start therapy. One could consider a “wait-and-see” approach with institution of antibiotics and granulocyte colony-stimulating factor (G-CSF; see “Granulopoeisis-stimulating agents”) for febrile episodes. However, this is not the authors' recommendation.
How do we evaluate the treatment response?
Response to treatment must be determined by periodic clinical and blood count assessments. The primary response criteria are defined using blood count results 4 months after starting therapy.
Hematologic complete response (CR) is defined as the complete normalization of blood counts (ie, hemoglobin > 12g/dL, platelets > 150 × 109/L, ANC > 1.5 × 109/L, and lymphocytosis < 4 × 109/L), and circulating LGL in the normal range. The number of LGL can be quantitated using FCM. Complete molecular remission is documented by the disappearance of T-cell clone using PCR.
Hematologic partial response is defined as an improvement in blood counts that do not meet criteria for complete remission (eg, ANC > 500 or decreasing transfusion requirements).
Treatment failure is defined as any response not meeting these criteria within 4 months after the beginning of the treatment.
Progressive disease is the worsening of cytopenia or organomegaly.
Review of therapeutic approaches
There is no standard treatment for patients with LGL leukemia. The numerous case reports published do not provide a consensus for selection of a particular therapeutic. All the 6 large series published in the literature so far (which we defined as those collecting data on more than 40 patients) are retrospective.2,10-12,59,63 Data are very heterogeneous, and treatment outcome per single agent is available for very few patients. If the overall response rate is mentioned, time to response, response and treatment duration, and time to treatment failure are frequently missing. Prospective trials involving large numbers of patients have not been published. However, it is clear that immunosuppressive therapy remains the foundation of treatment, including single agents methotrexate (MTX), oral cyclophosphamide, and cyclosporine (CyA). The following section briefly reviews published data on treatment outcome; more extensive summary of data are provided (see Tables 3,Table 4,Table 5,Table 6,Table 7–Table 8).
Steroids
The effects of prednisone in the treatment of LGL leukemia are disappointing. Monotherapy with prednisone may relieve some symptoms (ie, articular pains in case of RA) and temporarily improve neutropenia, but remissions are usually not durable. In a recent series, only 2 of 22 patients responded after using steroid alone as first-line therapy.12 It was ineffective in correcting neutropenia and reducing LGL clones. Adjunctive prednisone therapy may provide a more rapid hematologic improvement while first-line immunosuppressive agents are being initiated.
Granulopoeisis-stimulating agents
Granulocyte-macrophage colony-stimulating factor is no longer available but had been shown to significantly improve neutrophil count in some patients, although with side effects.64 G-CSF delivered as a single agent does not appear to be very effective in the treatment of LGL leukemia-associated neutropenia. It may induce transient improvement of neutropenia while immunosuppressive regimens take effect,65 but a significant proportion of patients will be refractory or have a mild and transient response. Exacerbation of splenomegaly and articular pains have also been reported. One might consider a single G-CSF injection to test the potential myeloid progenitor mobilization for a patient with asymptomatic neutropenia. If a positive response occurs, G-CSF could be administered at the time of neutropenic fever along with appropriate antibiotics.
Erythropoietin
There are a few case reports of therapy with erythropoietin in LGL leukemia patients having isolated and symptomatic anemia. In the French series, 2 of 7 patients had a partial but transient response.12 It has occasionally been used in association with immunosuppressive agents. Patients initially treated with CyA had conversion of partial response status to complete response after addition of erythropoietin.66,67 It is not mentioned whether these responding patients had low erythropoietin plasma levels. We do not recommend erythropoietin in the case of pure red cell aplasia.
MTX
RA is associated with LGL leukemia in approximately 20% of cases (Table 3). MTX has been widely used in RA over the 3 last decades and may improve both rheumatic symptoms and associated neutropenia. In 1994, we reported the efficacy of MTX in a prospective study.68 Ten patients with T-LGL leukemia were treated using 10 mg/m2 of MTX administered weekly, with or without prednisone. Five patients entered hematologic complete response, and 3 of them had molecular response with disappearance of T-cell clone. The mean duration of response was 3.8 years (range, 1.3-9.6 years). These results were confirmed in further series, and MTX has been mainly proposed as first-line therapy.59,65,69
Summary of results for MTX therapy in patients with LGL leukemia
| No. of patients . | Time to response, wk . | ORR, % . | CHR, % . | PR, % . | Duration of treatment, mo . | Duration of response, mo . | Comments . | Reference (year) . |
|---|---|---|---|---|---|---|---|---|
| 10 | 2-12 | 60 | 50 | 10 | NR | 12-108 | 3 MR | 68 (1994) |
| 2 | NR | 100 | NR | NR | NR | NR | NR | 59 (1994) |
| 4* | 8-12 | 100 | 67 | 33 | 16-54 | NR | 2 MR | 70 (2001) |
| 7 | 3-6 | 85 | 14 | 71 | 3-32 | NR | 2 responses after increasing doses to > 10 mg/m2 | 65 (2006) |
| 8 | NR | 38 | NR | NR | NR | NR | 1 response/3 as second-line therapy | 13 (2009) |
| 3 | NR | 66 | 33 | 33 | 12-36 | NR | NR | 69 (2010) |
| 62 | 4-12 | 55 | 21 | 34 | NR | 21 (12-60) | 12 relapses/18 under therapy | 12 (2010) |
| Total (n = 96) | 56/96 (56%) |
| No. of patients . | Time to response, wk . | ORR, % . | CHR, % . | PR, % . | Duration of treatment, mo . | Duration of response, mo . | Comments . | Reference (year) . |
|---|---|---|---|---|---|---|---|---|
| 10 | 2-12 | 60 | 50 | 10 | NR | 12-108 | 3 MR | 68 (1994) |
| 2 | NR | 100 | NR | NR | NR | NR | NR | 59 (1994) |
| 4* | 8-12 | 100 | 67 | 33 | 16-54 | NR | 2 MR | 70 (2001) |
| 7 | 3-6 | 85 | 14 | 71 | 3-32 | NR | 2 responses after increasing doses to > 10 mg/m2 | 65 (2006) |
| 8 | NR | 38 | NR | NR | NR | NR | 1 response/3 as second-line therapy | 13 (2009) |
| 3 | NR | 66 | 33 | 33 | 12-36 | NR | NR | 69 (2010) |
| 62 | 4-12 | 55 | 21 | 34 | NR | 21 (12-60) | 12 relapses/18 under therapy | 12 (2010) |
| Total (n = 96) | 56/96 (56%) |
ORR indicates overall response rate; CHR, complete hematologic response; PR, partial response; NR, not reported; and MR, molecular response.
One patient experienced MTX-related pneumonitis.
In a larger series of 62 patients, we recently demonstrated that the 55% overall response rate was slightly lower than that reported in the limited series and that a significant proportion of patients relapsed on therapy. Indeed, 12 of 18 patients (67%) followed more than one year relapsed, raising the question of the long-term efficacy of such treatment. Time to response ranged from 2 to 12 weeks.12 Treatment should not be pursued after 4 months in nonresponders. On the other hand, the duration of treatment is not defined. Generally, as MTX is well tolerated, it is continued indefinitely. Gradual reemergence of neutropenia has been seen even in patients achieving complete molecular remission. Physicians must be aware of side effects. Hepatic function should be evaluated while on therapy. Increased values of liver enzymes may occur requiring at least temporary cessation. Lung dysfunction has been reported with hypersensitivity pneumonitis.70 An ECOG protocol evaluating response to initial therapy with MTX (10 mg/m2 per week) closed to accrual after enrollment of 59 patients. Data analyses are in progress.
Cyclophosphamide
Cyclophosphamide, an alkylating agent, may be used successfully in T or NK LGL leukemia at a daily oral dose of 50 to 100 mg (Table 4). It appears that oral cyclophosphamide instead of MTX has been preferentially used in LGL leukemia patients with pure red cell aplasia. We and others have observed complete response in cases of neutropenia. The cyclophosphamide response rate compares favorably with that of MTX, with an ORR of 66% and 55%, respectively, in the French series.13,59,65,71,72 Time to response ranges from one to 4 months in our experience. Importantly, we have reported that 11 of 15 patients responded to cyclophosphamide after having failed to respond to MTX.12 Our data suggest that cyclophosphamide could be also considered as a first-line therapy. We recommend treating patients no longer than 4 months for nonresponders and 6 to 12 months for responders.
Summary of results for cyclophosphamide therapy in patients with LGL leukemia
| No. of patients . | Duration of treatment, mo . | Time to response, wk . | ORR, % . | CHR, % . | Comments . | Reference (year) . |
|---|---|---|---|---|---|---|
| 9 | 6-12 | — | 65† | — | All patients had PRCA | 71 (2001) |
| 16 | 12 | — | 69‡ | — | 13 as second-line 80% responses unmaintained | 59 (1994) |
| 4* | 1.3-10 | 4 | 33 | 33 | 1 CHR > 7 years | 65 (2006) |
| 8 | 24 (10-124) | 1 | 75 | — | All patients had PRCA | 72 (2008) |
| 16 | — | — | 44 | — | 11 of 16 as a second-line | 13 (2009) |
| 32 | 6-12 | — | 66 | — | First-line: n = 4, second-line n = 12, third-line: n = 16, 6 CR 12-48 mos after therapy cessation | 12 (2010) |
| Total (n = 85) | 52/85 (61%) |
| No. of patients . | Duration of treatment, mo . | Time to response, wk . | ORR, % . | CHR, % . | Comments . | Reference (year) . |
|---|---|---|---|---|---|---|
| 9 | 6-12 | — | 65† | — | All patients had PRCA | 71 (2001) |
| 16 | 12 | — | 69‡ | — | 13 as second-line 80% responses unmaintained | 59 (1994) |
| 4* | 1.3-10 | 4 | 33 | 33 | 1 CHR > 7 years | 65 (2006) |
| 8 | 24 (10-124) | 1 | 75 | — | All patients had PRCA | 72 (2008) |
| 16 | — | — | 44 | — | 11 of 16 as a second-line | 13 (2009) |
| 32 | 6-12 | — | 66 | — | First-line: n = 4, second-line n = 12, third-line: n = 16, 6 CR 12-48 mos after therapy cessation | 12 (2010) |
| Total (n = 85) | 52/85 (61%) |
ORR indicates overall response rate; CHR, complete hematologic response; —, not applicable; PRCA, pure red cell aplasia; and CR, complete response.
A total of 50-100 mg/day or 250-500 mg intravenously.
Four of 5 patients responded as front-line therapy.
A total of 80% as second-line therapy.
Cyclosporine
Whereas MTX has been considered by many physicians as the standard first-line therapy, CyA could be proposed as an alternative first-line/second-line therapy, particularly for patients with anemia (Table 5).12,13,65-67,69,72-75 Response rates vary from one study to another and are usually better in the small series. Patients with pure red cell aplasia appear to have a good response. Clinical responses usually occur without eradication of the leukemic LGL clone, and relapses on therapy are not rare. CyA must be continued indefinitely as disease manifestations usually recur rapidly with discontinuation of therapy. Side effects frequently lead to drug discontinuation and renal function and blood pressure have to be carefully monitored. In one series, HLADR4 (which is observed in 32% of LGL leukemia and 90% in cases of associated with RA) was highly predictive of CyA responsiveness.67
Summary of results for cyclosporine A therapy in patients with LGL leukemia
| No. of patients . | Treatment dosage . | Indication . | Time to response, % (wk) . | ORR . | Comments . | Reference (year) . |
|---|---|---|---|---|---|---|
| 3 | 600 mg/day | Anemia | 2-8 | 100 | CyA after steroid and Cytoxan failure | 73 (1996) |
| 5 | 2-3 mg/kg per day | Neutropenia/anemia | 3-9 | 100 | 1 CR achieved by adding GM-CSF | 74 (1998) |
| 25 | 5-10 mg/kg per day | Neutropenia/anemia | 9 | 56 | Response associated with DR4 phenotype 10 sustained responses; CR achieved by EPO | 67 (2003) |
| 23 | NR | Neutropenia/anemia | 2-60 | 78 | Response achieved by EPO | 65 (2006) |
| 9 | 225-350 mg/day | Neutropenia/anemia | 4-60 (4) | 40 | Response duration: on medications 9 months | 75 (2007) |
| 5 | 200 mg/day | PRCA (n = 5) | 2 | 25 | 2/5 relapses | 72 (2008) |
| 23 | NR | Neutropenia/anemia | NR | 44 | 16 as primary treatment | 13 (2009) |
| 10 | 2-3 mg/kg per day | PRCA (n = 2) | 11 | 70 | 3 CR after EPO/G-CSF | 66 (2010) |
| 6 | 100-150 mg/day | Neutropenia/anemia | NR | 50 | 2 dropout for SAE | 69 (2010) |
| 24 | 3-5 mg/kg per day | Neutropenia/anemia | 12-24 | 21 | 6 dropout for SAE | 12 (2010) |
| Total (n = 123) | 69/123 (56%) |
| No. of patients . | Treatment dosage . | Indication . | Time to response, % (wk) . | ORR . | Comments . | Reference (year) . |
|---|---|---|---|---|---|---|
| 3 | 600 mg/day | Anemia | 2-8 | 100 | CyA after steroid and Cytoxan failure | 73 (1996) |
| 5 | 2-3 mg/kg per day | Neutropenia/anemia | 3-9 | 100 | 1 CR achieved by adding GM-CSF | 74 (1998) |
| 25 | 5-10 mg/kg per day | Neutropenia/anemia | 9 | 56 | Response associated with DR4 phenotype 10 sustained responses; CR achieved by EPO | 67 (2003) |
| 23 | NR | Neutropenia/anemia | 2-60 | 78 | Response achieved by EPO | 65 (2006) |
| 9 | 225-350 mg/day | Neutropenia/anemia | 4-60 (4) | 40 | Response duration: on medications 9 months | 75 (2007) |
| 5 | 200 mg/day | PRCA (n = 5) | 2 | 25 | 2/5 relapses | 72 (2008) |
| 23 | NR | Neutropenia/anemia | NR | 44 | 16 as primary treatment | 13 (2009) |
| 10 | 2-3 mg/kg per day | PRCA (n = 2) | 11 | 70 | 3 CR after EPO/G-CSF | 66 (2010) |
| 6 | 100-150 mg/day | Neutropenia/anemia | NR | 50 | 2 dropout for SAE | 69 (2010) |
| 24 | 3-5 mg/kg per day | Neutropenia/anemia | 12-24 | 21 | 6 dropout for SAE | 12 (2010) |
| Total (n = 123) | 69/123 (56%) |
ORR indicates overall response rate; PRCA, pure red cell aplasia; NR, not reported; CyA, cyclosporine A; CR, complete response; GM-CSF, granulocyte-macrophage colony-stimulating factor; EPO, erythropoietin; G-CSF, granulocyte colony-stimulating factor; and SAE, serious adverse event.
Purine analogs
Experience with purine analogs (Table 6) is limited as less than 40 patients have been reported to be treated.12,65,69,76-82 The overall response rate is impressive (30 of 38 cases, 79%), but caution is indicated because of the very small number of cases. Toxicity seems acceptable and molecular remission is frequently confirmed. Response is usually observed after the first course of treatment. Three patients receiving purine analogs as initial therapy (2 receiving fludarabine with mitoxantrone and dexamethasone and 1 receiving fludarabine and dexamethasone alone) achieved and remained in complete remission, with median a follow-up time of 36 months. The same authors also described experience with fludarabine with mitoxantrone and dexamethasone in 9 patients with therapy-refractory T-LGL leukemia.79 Two of these patients were in continuous remission for 6 and 7 years. The advantages of purine analogs are a short period of treatment (one to 4-6 monthly courses), mild toxicity, high response rate, and the potential of inducing durable remission. A prospective clinical trial using purine analogs should be considered.
Summary of results for purine analogs based therapy in patients with LGL leukemia
| No. of patients . | Treatment . | ORR . | Duration of response (mo) . | Comments . | Reference (year) . |
|---|---|---|---|---|---|
| 1 | 2CDA | 1/1 (after 2 courses) | — | — | 76 (1997) |
| 1 | F | 1/1 | — | — | 77 (2003) |
| 1 | DCF | 1/1 | > 12 | — | 78 (2003) |
| 9 | FND | 9/9 | 13-35 | 8 patients had PRCA; 7 MR | 79 (2004) |
| 4 | DCF | 3/4 | — | — | 65 (2006) |
| 3 | FND | 3/3 | 12-40 | 2 MR | 80 (2007) |
| 2 | DCF/A | 0/2 | Toxic; | 75 (2007) | |
| 1 | DCF | 1/1 | > 13 | no MR | 81 (2008) |
| 9 | DCF | 7/9 | 3 | Time to treatment failure 7-10 mo | 69 (2010) |
| 4 | DCF | 3/4 | — | Complications: 1 case of AIHA | 12 (2010) |
| 3 | F | 1/3 | > 28 | — | 82 (2010) |
| Total n = 38 | 30/38 (79%) | — | — |
| No. of patients . | Treatment . | ORR . | Duration of response (mo) . | Comments . | Reference (year) . |
|---|---|---|---|---|---|
| 1 | 2CDA | 1/1 (after 2 courses) | — | — | 76 (1997) |
| 1 | F | 1/1 | — | — | 77 (2003) |
| 1 | DCF | 1/1 | > 12 | — | 78 (2003) |
| 9 | FND | 9/9 | 13-35 | 8 patients had PRCA; 7 MR | 79 (2004) |
| 4 | DCF | 3/4 | — | — | 65 (2006) |
| 3 | FND | 3/3 | 12-40 | 2 MR | 80 (2007) |
| 2 | DCF/A | 0/2 | Toxic; | 75 (2007) | |
| 1 | DCF | 1/1 | > 13 | no MR | 81 (2008) |
| 9 | DCF | 7/9 | 3 | Time to treatment failure 7-10 mo | 69 (2010) |
| 4 | DCF | 3/4 | — | Complications: 1 case of AIHA | 12 (2010) |
| 3 | F | 1/3 | > 28 | — | 82 (2010) |
| Total n = 38 | 30/38 (79%) | — | — |
ORR indicates overall response rate; 2CDA, 2-chlorodeoxyadenosine: F, fludarabine; DCF, deoxycoformycine; FND, fludarabine-mitoxantrone-dexamethasone; —, not applicable; PRCA, pure cell aplasia; MR, molecular response; and AIHA, autoimmune hemolytic anemia.
Campath
Alemtuzumab, a humanized monoclonal antibody against glycophosphatidylinositol- anchored CD52, is approved for use in chronic lymphocytic leukemia patients having failed fludarabine therapy (Table 7). It is also considered standard initial therapy for T prolymphocytic leukemia. The overall response rate on 26 patients is reported at more than 60%.12,13,69,75,83-88 However, toxicity limits use of this drug in an indolent disease. Furthermore, CD52 has significantly lower expression in leukemic LGL compared with CD8+ normal T cells, and this could explain therapeutic failure in some patients. We suggest that Campath be limited to refractory cases. Prophylactic antibiotics and cytomegalovirus monitoring are necessary.
Summary of results for Campath in patients with LGL leukemia
| No. of patients . | Indication . | Response . | Duration of response . | Reference (year) . |
|---|---|---|---|---|
| 1 | Refractory patients: PRCA | 1 | 11 and 24 mo | 83 (2003) |
| 1 | Refractory patients: pancytopenia | 1 | 80 wk | 84 (2004) |
| 1 | PRCA | 1 | 6 mo | 85 (2005) |
| 1 | Refractory patients: PRCA | 1 | > 9 mo | 86 (2005) |
| 3 | 2 with pentostatin | 1/3 (1 death) | Short | 75 (2007) |
| 2 | — | 1 PR/2 | — | 87 (2009) |
| 2 | Refractory patients | 2/2 | 11 and 24 mo | 69 (2010) |
| 4 | Anemia/neutropenia | 1/4* | — | 12 (2010) |
| 8 | 5 patients; transfusion-dependent | 4/8 | NS | 13 (2009) |
| 1 | Refractory patient/neutropenia | Yes (molecular response) | > 12 mo | 88 (2010) |
| Total (n = 24) | 14/24 (58%) |
| No. of patients . | Indication . | Response . | Duration of response . | Reference (year) . |
|---|---|---|---|---|
| 1 | Refractory patients: PRCA | 1 | 11 and 24 mo | 83 (2003) |
| 1 | Refractory patients: pancytopenia | 1 | 80 wk | 84 (2004) |
| 1 | PRCA | 1 | 6 mo | 85 (2005) |
| 1 | Refractory patients: PRCA | 1 | > 9 mo | 86 (2005) |
| 3 | 2 with pentostatin | 1/3 (1 death) | Short | 75 (2007) |
| 2 | — | 1 PR/2 | — | 87 (2009) |
| 2 | Refractory patients | 2/2 | 11 and 24 mo | 69 (2010) |
| 4 | Anemia/neutropenia | 1/4* | — | 12 (2010) |
| 8 | 5 patients; transfusion-dependent | 4/8 | NS | 13 (2009) |
| 1 | Refractory patient/neutropenia | Yes (molecular response) | > 12 mo | 88 (2010) |
| Total (n = 24) | 14/24 (58%) |
PRCA indicates pure cell aplasia; —, not applicable; PR, partial response; and NS, not significant.
Two deaths of infection.
Chemotherapy
Single-agent refractory patients or those with very aggressive presentation have been treated with CHOP-like (Cytoxan, hydroxyrubicin, Oncovin, prednisone) or other lymphoma regimens without efficacy. Typically, chronic exposure to low-dose therapy seems more efficient than sequential high-dose therapy. We and others have observed patients refractory to chemotherapy responding to single agents, such as MTX or cyclophosphamide. Allogeneic stem cell transplantation has been performed in only a few patients.89 Occasional successful outcomes have been reported, although notably one case report describes a patient refractory to transplant who responded to MTX.90 In summary, “lymphoma therapy” or stem cell transplantation has no role in therapy of LGL leukemia.
Splenectomy
Splenectomy has been proposed for correcting neutropenia, hemolytic anemia, or symptomatic splenomegaly (Table 8). Overall, 31 of 55 patients (56%) responded to splenectomy.12,13,59,91-94 Only 3 series of more than 10 patients have been published. The last 2 series show disappointing results.12,13
Summary of results for splenectomy in patients with LGL leukemia
| No. of patients . | Indication . | Response . | Comments . | Reference (year) . |
|---|---|---|---|---|
| 4 | Neutropenia | 2/4 | 1 patient died; 2 sustained response | 91 (1987) |
| 8 | ? | 5/8 | — | 59 (1994) |
| 1 | Thrombocytopenia | 1/1 | Normalization of platelet count; death of patient 2 years later | 92 (1991) |
| 1 | AIHA | 1/1 | Normalization of Hb level | 53 (1998) |
| 1 | ? | No | — | 93 (1998) |
| 15 | Splenomegaly; cytopenias | 13/15 | 13/15 sustained response; 2 patients died | 94 (2008) |
| 12 | ? | 5/12 | — | 13 (2009) |
| 13 | Splenomegaly; cytopenias | 4/13 | — | 12 (2010) |
| Total (n = 55) | 31/55 (56%) |
| No. of patients . | Indication . | Response . | Comments . | Reference (year) . |
|---|---|---|---|---|
| 4 | Neutropenia | 2/4 | 1 patient died; 2 sustained response | 91 (1987) |
| 8 | ? | 5/8 | — | 59 (1994) |
| 1 | Thrombocytopenia | 1/1 | Normalization of platelet count; death of patient 2 years later | 92 (1991) |
| 1 | AIHA | 1/1 | Normalization of Hb level | 53 (1998) |
| 1 | ? | No | — | 93 (1998) |
| 15 | Splenomegaly; cytopenias | 13/15 | 13/15 sustained response; 2 patients died | 94 (2008) |
| 12 | ? | 5/12 | — | 13 (2009) |
| 13 | Splenomegaly; cytopenias | 4/13 | — | 12 (2010) |
| Total (n = 55) | 31/55 (56%) |
AIHA indicates autoimmune hemolytic anemia; —, not applicable; and Hb, hemoglobin.
New drugs
A phase 2 study investigating use of farnesyltransferase inhibitor, tipifarnib (Zarnestra, Johnson & Johnson), enrolled a total of 8 patients. The rationale for this study was based on preclinical data showing that constitutively activated Ras is a survival pathway in leukemic LGL.37 No hematologic responses were observed. However, promising biologic activity was demonstrated as evidenced by findings of decreased LGL in blood and marrow, improved marrow hematopoiesis, and increased hematopoietic colony growth in vitro (P. Epling-Burnette, T. P. Loughran Jr, unpublished observations, December 2009). There was remarkable improvement in signs of pulmonary hypertension in one patient.48 A phase 1 study with an anti-CD2 monoclonal antibody (siplizumab) is enrolling patients who failed at least one prior therapy. Humanized MiK-β-1 monoclonal antibody is being tested in a phase 1 trial in patients with T-LGL leukemia (www.clinicaltrials.gov; #NCT00079196). This antibody is directed toward CD122, a common subunit of interleukin-2 and interleukin-15 receptors.
Our therapeutic recommendations
Our therapeutic approach is summarized in Figure 5. MTX at 10 mg/m2 orally taken weekly (at split doses of 5 mg/m2 in the morning and 5 mg/m2 at night) is our initial choice for treatment of LGL patients with neutropenia. If such patients have severe neutropenia (ANC < 200), then we add prednisone at 1 mg/kg per day orally for the first month, with tapering off by the end of the second month. For LGL patients with anemia, MTX on the same schedule is the choice of one of the authors (T.P.L.), whereas cyclophosphamide at 100 mg orally daily is the first choice of the other author (T.L.). Immunosuppressive therapy is continued for 4 months, and then the patient is evaluated for response. In case of failure of primary therapy, cyclophosphamide (100 mg orally daily) is initiated by one of the authors (T.P.L.); the second author (T.L.) also chooses cyclophosphamide for neutropenia patients but uses CyA for anemic patients. CyA is not used much by one of the authors (T.P.L.) and is reserved for patients failing both MTX and cyclophosphamide. Both MTX and CyA are maintained indefinitely as long as these medications are reasonably tolerated and disease response is maintained. In contrast, cyclophosphamide therapy is limited to 6 to 12 months because of the risk of bladder toxicity and mutagenesis. For relapsing patients, depending on the time to treatment failure, we propose to resume the initial treatment or opt for an alternative immunosuppressive drug that has not been previously tested.
We define a refractory patient as one who fails the 3 major immunosuppressive drugs (MTX, cyclophosphamide, and CyA). The optimal strategy for refractory patients is difficult to assess. Purine analogs may be considered as well as Campath. Splenectomy is also an option for such patients. As none of these therapeutic modalities can cure LGL leukemia, newer treatments are needed. Enrollment on clinical trials is encouraged. Participation in the U.S. national LGL Leukemia Registry or the French LGL Registry is welcomed.
The publication costs of this article were defrayed in part by page charge payment. Therefore, and solely to indicate this fact, this article is hereby marked “advertisement” in accordance with 18 USC section 1734.
Acknowledgments
The authors thank Drs William Morice and Curtis Hanson of Mayo Clinic for providing Figure 3 and Dr Mikael Roussel of Hematologie Immunology of Therapic Cellulaire (HITC) Department (Rennes University Hospital, France) for providing Figure 4.
This work was supported in part by the National Institutes of Health grants CA094872 and CA133525.
National Institutes of Health
Authorship
Contribution: T.L. and T.P.L. wrote the manuscript.
Conflict-of-interest disclosure: The authors declare no competing financial interests.
Correspondence: Thierry Lamy, Department of Hematology, Service d'Hematologie, Hopital Pontchaillou, Centre Hospitalier Universitaire de Rennes, 35033 Rennes, France; e-mail: thierry.lamy@univ-rennes1.fr; or Thomas P. Loughran Jr, Department of Medicine, Penn State Hershey Cancer Institute, 500 University Dr CH72, Hershey, PA 17033; e-mail: tloughran@psu.edu.

This feature is available to Subscribers Only
Sign In or Create an Account Close Modal